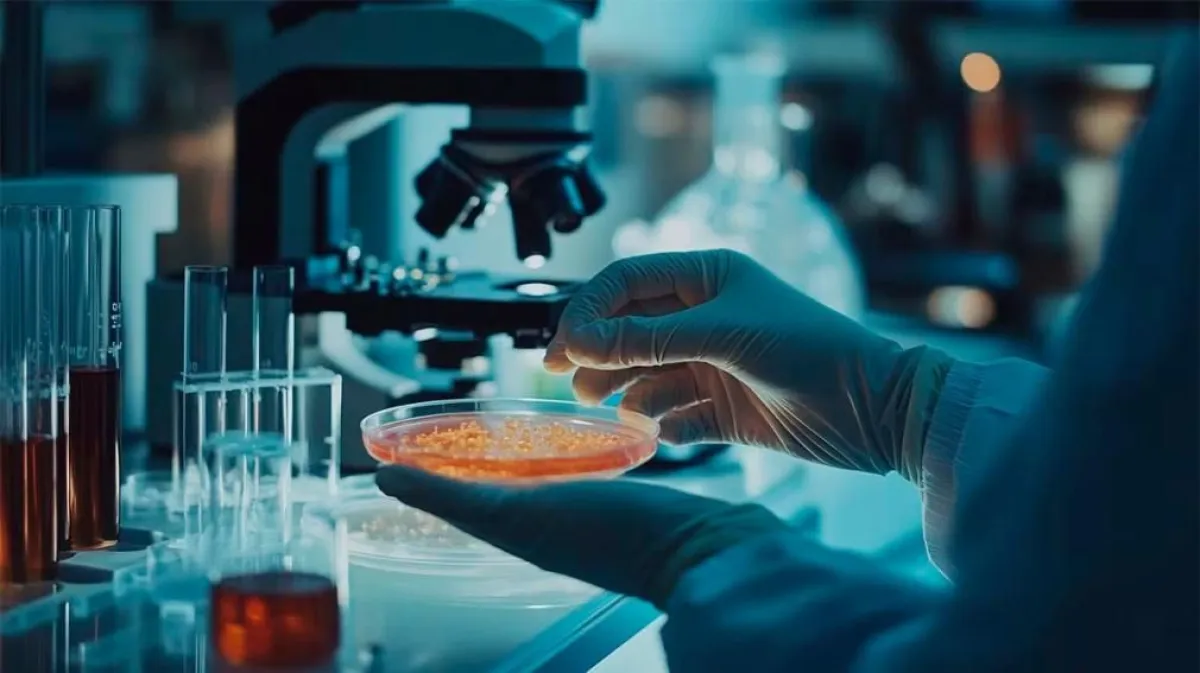

Sanciones: la ANMAT inhabilitó a ocho laboratorios por irregularidades

La Administración Nacional de Alimentos, Medicamentos y Tecnología Sanitaria (ANMAT) ha implementado medidas drásticas contra determinadas empresas dentro del sector farmacéutico. Este movimiento responde a la necesidad urgente de asegurar el cumplimiento de normas esenciales de control y seguridad que protejan la salud pública. La decisión surge tras un cambio de liderazgo en la institución, ahora encabezada por Luis Fontana.
Luis Fontana asumió el cargo tras la salida de Agustina Bisio. Esta ex titular está bajo la lupa judicial debido a una investigación relacionada con la comercialización de fentanilo contaminado, un caso que en su momento convulsionó al país. Las decisiones actuales indican un cambio de rumbo hacia una vigilancia más estricta y rigurosa del sector. Dentro de las primeras maniobras dirigidas por Fontana, se encuentra la inhibición de operaciones para Biotenk y Laboratorios Solkotal, dos empresas que hasta hace poco gozaban de actividad dentro del mercado.
Estas medidas no son arbitrarias, sino producto de investigaciones llevadas a cabo por el Instituto Nacional de Medicamentos (Iname). En el caso de Biotenk, ubicada en Villa Lugano, se identificaron fallos significativos en su departamento de farmacovigilancia y la carencia de un sistema de notificación eficiente para reacciones adversas. Tales carencias representan una amenaza potencial para la comunidad. ANMAT procedió a suspender su actividad tras el incumplimiento de la empresa de entregar un plan viable para corregir estas deficiencias.
Laboratorios Solkotal, otro nombre que resalta en esta situación crítica, había ya enfrentado problemas previos de cumplimiento. Su historia se remonta a 2022, cuando el Ministerio de Salud y Trabajo se unió para permitir un reinicio parcial de operaciones a condición de un seguimiento de sus actividades. No obstante, nuevas auditorías revelaron problemas continuos de infraestructura y defectos de calificación en su personal. Una situación que derivó en la directiva de ANMAT de prohibir su producción y promover el retiro del mercado de sus lotes circulantes.
Además, ocho laboratorios y droguerías han visto revocada su licencia de operación. Casos significativos como el de Laboratorio Apolo sobresalen por su conexión con la tragedia de Rosario en 2016, posteriormente llevado a juicio por su rol en la fabricación de fentanilo adulterado. Este panorama pinta una realidad grave y deja entrever la importante tarea que Luis Fontana y ANMAT tienen por delante: restablecer la confianza y la seguridad en la cadena farmacéutica nacional.
Según fundamentó la autoridad regulatoria, la medida se adoptó en el marco de un control del Registro de Inscripción de Establecimientos, donde se constató que ninguna de las firmas contaba con actividad productiva ni con un director técnico designado, un requisito obligatorio establecido por la Ley Nº 16.463.
En paralelo, la Anmat también dispuso la prohibición del uso, comercialización y distribución de dos sistemas de stent carotídeos, luego de que se denunciara el robo de esas unidades durante su traslado.













